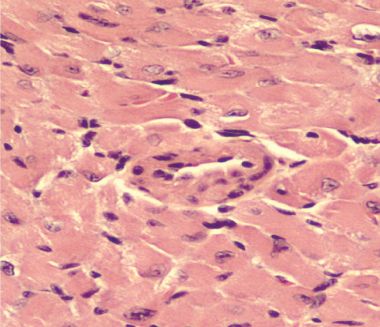

This image shows a section of a transplanted heart in a mouse that was given only CTLA4-Ig, a standard anti-rejection therapy. A large number of infiltrating immune cells are visible by their blue-staining nuclei, showing that the heart is undergoing rejection. Heart muscle cell nuclei are also stained blue. All images: “Brief treatment with a highly selective immunoproteasome inhibitor promotes long-term cardiac allograft acceptance in mice.” Karreci, Esilida Sula. PNAS, 2016. doi: 10.1073/pnas.1618548114
An experimental drug that blocks the activation of an immune cell component effectively prevented rejection of heart transplants in mice, according to new research from scientists at Weill Cornell Medicine and Brigham and Women’s Hospital.
The findings, published Dec. 12 in Proceedings of the National Academy of Sciences, describe a compound developed by Weill Cornell Medicine investigators that inhibits cellular structures called immunoproteasomes while sparing closely related structures called constitutive proteasomes. Proteasomes help cells regulate their behavior by breaking down regulatory proteins. Constitutive proteasomes are found in all cells, while immunoproteasomes are expressed chiefly in cells of the immune system.
Currently approved proteasome inhibitors target both types of proteasomes equally. They are used in transplant medicine to block immune cell function and reduce the rejection of the transplanted organs. However, inhibition of proteasomes in all cells throughout the body can cause toxicity in both the transplanted organ and the host. In their study, the investigators demonstrated that their compound, a highly selective and reversible immunoproteasome inhibitor called DPLG3, only shuts down immunoproteasomes, leaving constitutive proteasomes unscathed. DPLG3 reduced the number of immune cells in the graft. The inhibitor also increased the expression of “exhaustion markers” on the remaining immune cells. Exhaustion markers are typical of immune cells that have dialed down their ability to attack foreign cells. These changes protect the organ from rejection, while sparing the body from the toxic side effects of non-selective proteasome inhibitors, such as damage to the bone marrow and nervous system.
This image shows a section of a transplanted heart in a mouse given CTLA4-Ig together with the immunoproteasome inhibitor DPLG3. The heart looks normal. There are almost no immune cells, only nuclei of heart muscle.
“Transplant patients often have to continue toxic, broadly immunosuppressive agents for a long period of time, increasing the risks of infection, cancer and toxicity to the graft itself,” said co-senior author Dr. Carl Nathan, chairman of the Department of Microbiology and Immunology, the R.A. Rees Pritchett Professor of Microbiology, and a professor of microbiology and immunology and of medicine at Weill Cornell Medicine. “Selectively blocking immunoproteasomes — without affecting the constitutive proteasomes in other host cells and in the cells of the transplanted organ — could help patients with long-term acceptance of their grafts and improve the outlook for organ transplantation.”
Weill Cornell Medicine researchers, led by co-senior study author Dr. Gang Lin, an associate professor of research in microbiology and immunology, designed DPLG3 to be highly selective for immunoproteasomes and to remain highly selective during prolonged exposure, in contrast to other experimental agents directed at immunoproteasomes. Drs. Nathan and Lin are co-inventors of DPLG3, and have filed a patent for it.
Then, Dr. Jamil Azzi and his team at Brigham and Women’s Hospital tested DPLG3 on mice that received heart transplants. Mice given DPLG3 daily for 10 days after surgery accepted the transplanted hearts for an average of 13 days, compared with seven days for rodents that did not receive the compound. The researchers then combined a seven-day regimen of DPLG3 with a single dose of the immunosuppressive agent CTLA4-Ig, finding that the treatment protected the transplant for an average of 84 days, compared with 38.5 for mice receiving only CTLA4-Ig. A single dose of CTLA4-Ig and a 14-day DPLG3 program maintained the heart transplant for as long as the mice were studied — more than 100 days, on average — without any other treatment after day 14.
Dr. Nathan said that it is likely, based on work not included in the paper, that these compounds might be helpful in very different conditions that involve excessive inflammatory or immune reactions. “We think there's a lot of work to do to document whether this is the case and to improve the compounds in terms of basic pharmaceutical properties, but we think the possibilities are bright,” he said.
This research was supported by the American Heart Association, the Milstein Program in Translational Medicine and Chemical Biology, the Alliance for Lupus Research and the Daedalus Fund for Innovation at Weill Cornell Medicine.
